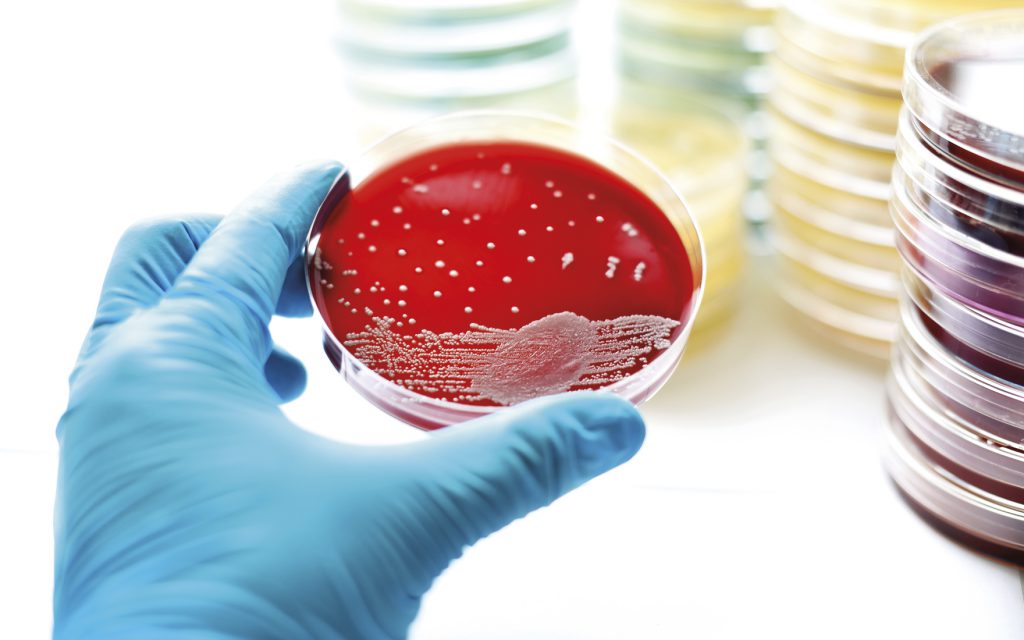

Antibiootit ovat mahdollistaneet 1930-luvulta lähtien modernin lääketieteen: infektioiden hoidon, kirurgiset toimenpiteet antibioottisuojassa ja syövän intensiivisen hoidon. Näiden ihmelääkkeiden tehon menetyksen takia maailmassa kuolee jo nyt arviolta 700 000 ihmistä vuosittain. On ennustettu, että mikrobilääkeresistenssi aiheuttaa peräti 10 miljoonaa kuolemaa vuonna 2050.
Uusia antibiootteja kehitettiin ja löydettiin aina 1980-luvun lopulle asti, mutta tämän jälkeen on ollut hiljaista. Samanaikaisesti bakteerit ovat onnistuneet muuntautumaan vastustuskykyisiksi, ja ollaan tilanteessa, jossa kaikille ongelmamikrobien aiheuttamille infektioille ei löydy enää tehokasta lääkitystä.
– Pienimmillään puhutaan 1–2 vuodesta, jonka aikana resistenssi on muodostunut, kertoo Turun yliopiston bakteriologian professori Jaana Vuopio.
Lääkeresistenssillä tarkoitetaan yleensä nk. hankittua resistenssiä, jossa lääkkeen käyttö muokkaa bakteerin vastustuskykyiseksi yhdelle tai usealle lääkkeelle. Tämä eroaa bakteerien luontaisesta resistenssistä, jolloin kyseessä on bakteerin ominaisuus.
Bakteeriresistenssi syntyy, kun lääke tuhoaa patogeenien lisäksi muitakin bakteereja, ja mikrobiomissa olleet muutamat lääkkeelle resistentit bakteerit pääsevät lisääntymään ja rikastumaan. Ongelmaa lisää, että jotkut resistentit bakteerit osaavat siirtää resistenssin myös toisiin bakteereihin.
– Bakteerit ovat resistenttejä – eivät ihmiset, Vuopio vielä painottaa.
Suomiko lintukoto?
Suomen ja muiden Pohjoismaiden tilanne on yhä melko hyvä, mutta asiantuntijat varoittavat tuudittautumasta tähän. Terveyden ja hyvinvoinnin laitoksen (THL) tartuntatautirekisterin mukaan tällä hetkellä yleisimpiä resistenttejä bakteereja Suomessa ovat ESBL-bakteerit (5 097 uutta tapausta v. 2016) ja MRSA-kannat (1 700 uutta tapausta v. 2016). Lisäksi Suomesta löytyy VRE:ja (v. 2016 71 tapausta) ja mm. hyvin resistenttejä CPE-bakteereita (muutama löydös / kk).
THL:n asiantuntija, dos. Jari Jalava nostaa kaksi huolenaihetta esille: resistenttien E. coli-kantojen (ESBL) ja karbapenemaasia tuottavien enterobakteerikantojen (CPE) vahvan nousun.
– Vaikka Suomessa ei voida puhua hätätilanteesta, tilanne on huolestuttava. ESBL-kantoja vastaan löytyy vielä lääkkeitä, vaikka perinteiset antibiootit eivät enää auta. CPE-kannat puolestaan ovat kehittyneet ja kehittyvät edelleen erittäin resistenteiksi, jolloin tulehduksiin on jo vaikea löytää lääkitystä.
Erikoishammaslääkäri Hannamari Välimaa muistuttaa, että näitä bakteereita voi löytyä myös suusta.
– Antibiooteille laajasti resistentit bakteerit, kuten MRSA ja ESBL, voivat satunnaisesti kolonisoida myös suun limakalvoja ja aiheuttaa suussa infektioita.
Suomellakaan ei siis ole varaa höllentää otettaan – päinvastoin. Avohoidon tilastot kertovat, että Suomessa käytetään enemmän antibiootteja kuin esimerkiksi muissa Pohjoismaissa. Viimeisimmän 2016 julkaistun Eurobarometrin mukaan 31 % suomalaisista aikuisista kertoi syöneensä antibioottikuurin viimeisen vuoden aikana. Samaisen barometrin mukaan kolmannes suomalaisista aikuisista luuli antibioottien tehoavan viruksiin.
Matkailijoiden matkassa
Globalisaatio ja kansainvälinen matkailu tehostavat resistenttien bakteerien leviämistä. Resistentit bakteerit kulkevat potilaiden ja tavallisten terveiden matkailijoiden mukana – yleensä oireettomasti matkailijan tietämättä. Suomalaisen tutkimuksen (2015) mukaan 21 % matkailijoista toi resistentin ESBL-kannan tuliaisena matkaltaan. Tuore 2017 Lancet Infectious Diseasessa julkaistu
tutkimus näyttää vielä suurempia prosenttilukuja.
– Kolme merkittävintä riskitekijää ovat riskimaihin matkustaminen, suoliston mikrobit sekoittava ripuli ja antibioottikuuri. Terveinä Intian niemimaalla matkanneista 23 % tuli ESBL:n kanssa takaisin. Jos he saivat ripulin, 47 % tuli ESBL:n kanssa takaisin. Jos he hoitivat ripulia antibiootilla, luku nousi 80 %:iin, kertoo Helsingin yliopiston infektiosairauksien professori Anu Kantele.
Kantele kertoo aivan tuoreesta tutkimuksestaan, joka osoitti, että antibioottikuurin syötyään matkailija poimii mukaansa kaikkien ESBL-kantojen joukosta nimenomaan ne, joiden resistenssikirjo on laajin. Tämä hankaloittaa mahdollisten infektioiden hoitoa entisestään. Resistentin kannan saamisen riskiä lisää sairaalahoito matkan aikana.
Resistentit bakteerit liikkuvat eläin- ja ihmispopulaation sekä ympäristön välillä jatkuvasti. Suomessakin ympäristöstä löytyy resistenttejä bakteereja, mutta mittakaava on aivan toinen, kun mennään tiheästi asutuille köyhille alueille esim. Intiaan tai Kaakkois-Aasiaan, jossa tuotetaan ja käytetään paljon antibiootteja, ja hygieniaolot ovat heikot.
– Antibiootteja myydään kaduilla, ja Thaimaassa tehdyn tutkimuksen mukaan yli 80 %:lla myyjistä ei ole terveydenhuollon koulutusta. Intiassa tuotetaan valtavasti antibiootteja ja myydään halvalla esim. Afrikkaan. Tehtaiden ympäristöpäästöt ovat merkittäviä. Monet paikalliset eivät edes tiedä, mitä antibiootit ovat, kuvailee Kantele.
Matkailua ei tarvitse lopettaa, mutta omista, hyvin pärjäävistä bakteereista kannattaa pitää huolta kaikin keinoin. Onneksi resistentit bakteerit myös poistuvat yleensä elimistöstä joidenkin kuukausien jälkeen ja aiheuttavat vain harvoin oireisen, vaikeahoitoisen infektiotaudin.
Varjele mikrobilääkkeiden tehoa
Paras tapa torjua resistenssiä on siis mikrobilääkkeiden harkittu käyttö, sillä ne vaikuttavat aina verenkierron kautta laaja-alaisesti ihon ja limakalvojen normaaliin mikrobistoon.
– Vaikutukset ulottuvat muuallekin kuin ensisijaisesti hoidon kohteena olevaan infektioon. Siksi antibioottia tulee käyttää vain tilanteessa, jossa sille on perusteltu tarve, toteaa Välimaa.
Mikrobilääkkeiden käytön tulisi olla niin pitkälle harkittua kuin mahdollista. Lääkkeitä käytetään toki silloin kun on tarvetta, mutta annostelun ja kuurien pituuden tulee olla perusteltuja. Lääkehoidon pitäisi hoitaa infektio, mutta ei päästä kehittämään resistenssiä.
– Suussa tavanomaisesti esiintyvien bakteerien herkkyys yleensä hammashoidossa käytettäville antibiooteille on säilynyt edelleen varsin hyvänä. Liian huoleton tai perusteeton antibioottien määrääminen voi heikentää suun bakteerien antibioottiherkkyyttä – oli antibiootti sitten määrätty suun infektioon tai muuhun tarkoitukseen, toteaa Välimaa.
YK:n yleiskokous listasi resistenssin torjuntakeinoiksi myös koulutuksen ja tutkimuksen, hyvän seurannan ja ehkäisyn sekä nopeat diagnostiset testit.
– Jos pystyisimme laboratoriokeinoin diagnosoimaan bakteerisairaudet nykyistä nopeammin ja tarkemmin, auttaisi se myös valitsemaan lääkehoidon täsmällisemmin, painottaa Vuopio.
Resistentit bakteerikannat leviävät maiden välillä myös eläinten ja elintarvikkeiden mukana. Suomi kuuluu niihin harvoihin maihin, joissa mikrobilääkkeillä ei saa edistää tuotantoeläinten kasvua ja joissa mikrobilääkkeiden käyttö eläimillä on tarkasti valvottua. Suomeen tuodaan kuitenkin paljon elintarvikkeita muualta, ja maailmalla mikrobilääkkeitä käytetään systemaattisesti tuotantoeläinten kasvun lisäämiseen sekä ennaltaehkäisemään mahdollisia sairauksia.
Torjuntaa ohjeiden ja seurannan avulla
Suomessa resistenssitilanne on pysynyt kansainvälisesti vertailtuna kohtuullisen hyvänä pääasiassa hallitusta antibioottien käytöstä ja hyvästä hygieniatasosta johtuen. Tukena ovat myös kattavat torjunta- ja seurantatoimet sekä alan ammattilaisten osaaminen.
Suomessa mikrobilääkeresistenssin seurantaa tekevät THL ja FiRe-verkostoon (Finnish Study Group for Antimicrobial Resistance) kuuluvat laboratoriot. Uusi, 1.3.2017 voimaan tullut tartuntatautilaki tehostaa mikrobilääkeresistenssin torjuntaa ja seurantaa velvoittamalla myös sosiaalialan laitoksia seuraaman resistenttejä kantoja sekä lääkkeiden käyttöä.
STM:n johdolla valmistellaan myös kansallista mikrobilääkeresistenssin torjunnan toimintaohjelmaa, joka kokoaa yhteen tiedot torjunnasta ja listaa ehdotuksia sen kehittämiseksi.
– Puutteita näyttäisi olevan esim. tarkemmassa alue- ja eläinlajikohtaisessa mikrobilääkkeiden käytön seurannassa ja kansallisissa infektioiden torjuntaohjeissa. Toimintaohjelma perustuu WHO:n malliin, jota muokataan Suomeen sopivaksi, kertoo Jalava.
Jalava muistuttaa, että Suomesta puuttuu yhä myös kansalliset mikrobilääkkeiden käyttöohjeet. Mikrobilääkkeiden käyttöä ohjeistetaan Suomessa kuitenkin mm. Käypä hoito -suosituksilla, joita päivitetään säännöllisesti. Hammaslääketieteellisen Hammasperäiset äkilliset infektiot ja mikrobilääkkeet -suosituksen päivitys on valmistumassa keväällä 2017. Sen tärkein viesti pysyy ennallaan: Mikrobilääke on toissijainen hammaslääketieteelliseen hoitoon nähden infektioiden hoidossa. Tarkempaan sisältöön ja tutkimusnäyttöön pureudutaan Hammaslääkärilehdessäkin suosituspäivityksen valmistuttua.
Mitä tilalle?
WHO julkaisi juuri listan resistenteistä bakteereista, joiden aiheuttamien infektioiden hoitoon tarvitaan nopeasti uusia antibiootteja. Kriittisessä kategoriassa ovat karbapeneemeille vastustuskykyiset moniresistentit (CPE)-kannat. Lääkkeiden kehittämiseen patisti myös YK:n Yleiskokouksen julkilausuma.
Tilanteen vakavuus on ymmärretty, mutta kilpajuoksua bakteerien kanssa on vaikea voittaa.
Suomessa ja kansainvälisesti etsitäänkin myös vaihtoehtoisia tai täydentäviä hoitokeinoja mikrobilääkkeiden tilalle. Viime aikoina esillä on ollut mm. bakteriofagihoito, jossa bakteereja vastaan hyökätään bakteriofagilla eli bakteereja tuhoavalla viruksella. Haasteena on juuri oikean fagin löytäminen.
Kilpailevia mikrobeja hyödynnetään puolestaan ulosteensiirroissa. Bakteereja on onnistuttu myös herkistämään uudelleen antibiooteille lääkkeiden avulla.
Rokotteet ovat yksi onnistunein tapa vähentää mikrobilääkkeiden käyttöä.
– Rokotteet ovat hyvä esimerkki myös positiivisesta kehityksestä. Esimerkiksi pneumokokkirokotusten avulla Streptococcus pneumoniae -bakteerien aiheuttamat vakavat infektiot ja niiden hoidon tarve ovat vähentyneet selkeästi. Myös pneumokokkibakteerien lääkeresistenssi on vähentynyt. Myös virustauteja torjuvat rokotteet vähentävät antibioottien käyttöä, sillä tarkkaa diagnoosia on välillä vaikea tehdä ja antibiootteja määrätään myös virusinfektioihin, muistuttaa Jalava.
Taistelussa hiljaista pandemiaa vastaan tarvitaan kaikkien panostusta – joka päivä.
Lähteet: Prof. Anu Kanteleen ja prof. Jaana Vuopion luennot Apollonian juhlasymposiumissa 9.–11.3.2017.
Dos. Jari Jalavan haastattelu 14.3.2017 ja erikoishammaslääkäri Hannamari Välimaan sähköpostihaastattelu 9.3.2017
Älä lintsaa käsihygieniasta
Resistentit bakteerit eivät pidä meteliä itsestään, eivätkä ne näy päällepäin. Ne etenevät huomaamatta, jos niiden annetaan edetä. Helpoiten ongelmamikrobit rikastuvat sairaaloissa ja pitkäaikaishoitolaitoksissa, mutta käytännössä jokainen vastaanotto on altis. Infektiosairauksien erikoislääkäri Katariina Kainulainen muistuttaa, että esim. vuonna 2016 HUS-alueen uusista MRSA-tapauksista noin 60 % oli potilailla, jotka eivät olleet olleet sairaalahoidossa.
Terveydenhuollon ammattilaisten on huolehdittava hyvän ja turvallisen hoidon edellytyksistä.
– Meidän velvollisuutemme on varmistaa, että potilas on turvassa, kun hän tulee meidän vastaanotollemme, riippumatta siitä, mitä vastaanoton ulkopuolella tapahtuu. Näin sanoo lakikin, toteaa Kainulainen.
Huolellisen mikrobilääkekäytön lisäksi resistenssin torjunta vaatii hyvää päivittäishygieniaa ja tarvittaessa tartuntatautitoimia. Suun terveydenhuollon alalla tartuntatautien torjunnalla on omat erityishaasteensa: lähes jokainen käyttää palveluita joskus, ala on toimenpidekeskeinen, ja käytössä on runsaasti laitteita sekä niiden vesijärjestelmiä. Hammaslääkäri hoitaa usein myös vaurioitunutta kudosta tai se rikkoutuu toimenpiteessä.
– Hammaslääkäri käsittelee usein aluetta, jossa limakalvo on rikki. On ihan selvää, että potilas altistuu mahdollisille käsissä oleville bakteereille, huomauttaa Kainulainen.
Pelkät suojakäsineet eivät riitä
Kainulainen korostaa, etteivät pelkät suojakäsineet riitä estämään bakteerien leviämistä.
– Me emme saa koskaan käyttää suojakäsineitä ilman, että käytämme käsihuuhdetta samalla. Käsihuuhde on käsihygienian perusta, suojakäsineet tulevat lisänä.
Jos suojakäsineet puetaan ilman käsien desinfiointia, käsinelaatikko ja juuri käteen puettavat käsineet kontaminoituvat käsissä olevilla bakteereilla. Vastaavasti riisuttaessa käsineitä potilaan mikrobit siirtyvät vähintään puolessa tilanteista käsien iholle. Käsihuuhdetta tuleekin käyttää aina myös suojakäsineiden riisumisen jälkeen. Vaikka saippuapesukin hoitaa desinfektoinnin, Kainulainen suosittelee käsihuuhteen käyttöä, sillä jatkuva saippuapesu kuluttaa käsiä ja pesu vaatii pidemmän ajan.
Toinen tärkeä ohje koskee vierasmateriaaleja käsissä. Vierasmateriaaleihin luetaan paitsi kellot ja sormukset, myös rakennekynnet ja kynsilakka.
– Vierasmateriaalit käsissä on kielletty! Käsien pitää olla kyynärpäistä sormien päihin asti tyhjät. Mitä enemmän vierasmateriaalia on, sitä huonommin käsihuuhde toimii, painottaa Kainulainen.
Ohjeet on tarkoitettu noudatettaviksi
Terveyden ja hyvinvoinnin laitoksen vuonna 2016 julkaisema Ohje suun terveydenhuollon yksiköiden tartunnantorjuntaan tarjoaa ohjeet varotoimenpiteisiin niin päivittäishygieniassa kuin resistenttien bakteerien osalta. Ohjeistukset ja hygieniakäytännöt on tarkoitettu sekä potilaan että suunterveyden ammattilaisten turvaksi.
– Koska emme voi varmasti tietää, kuka resistenttiä bakteeria kantaa, vastaanottotoiminnassa on ohjeena noudattaa riittäviä toimia tartuntateiden katkaisemiseksi jokaisen potilaan kohdalla, muistuttaa suun terveydenhuollon yksiköiden tartunnantorjuntaohjeen laatinut erikoishammaslääkäri Hannamari Välimaa.
Kainulainen korostaa, että ohjeiden noudattamisen tulisi olla itsestään selvää.
– Sääntöjä pitää noudattaa, vaikka niitä ei ymmärtäisikään, mutta niitä on helpompi noudattaa, jos säännöt ymmärtää.